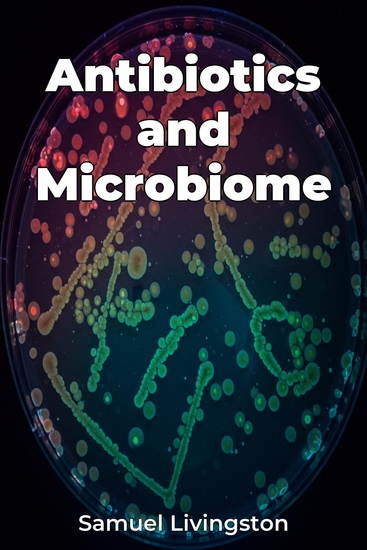

Antibiotics and Microbiome
Samuel Livingston
Traductor A AI
Editorial: Publifye
Sinopsis
Antibiotics and Microbiome explores the complex and crucial relationship between antibiotic use and the human microbiome—the vast community of microorganisms living within us. While antibiotics are vital for fighting bacterial infections, their widespread use significantly impacts the diversity and stability of our microbial ecosystems. The book reveals how antibiotics can disrupt the delicate balance of microbial communities, potentially leading to dysbiosis and a range of health issues, including increased susceptibility to infections and even mental health disorders via the gut-brain axis. The book approaches this topic by first introducing the human microbiome, detailing its composition and function. It then examines the direct effects of antibiotics on various microbial communities, highlighting how they can indiscriminately kill both beneficial and harmful bacteria. Progressing across chapters, it explores the long-term consequences of antibiotic-induced microbiome disruption, like antibiotic resistance, and potential mitigation strategies, such as fecal microbiota transplantation. Drawing from metagenomic studies and clinical trials, the book offers a balanced perspective on the benefits and risks of antibiotic use, making it valuable for students, researchers, healthcare professionals, and anyone interested in the science of life sciences.














